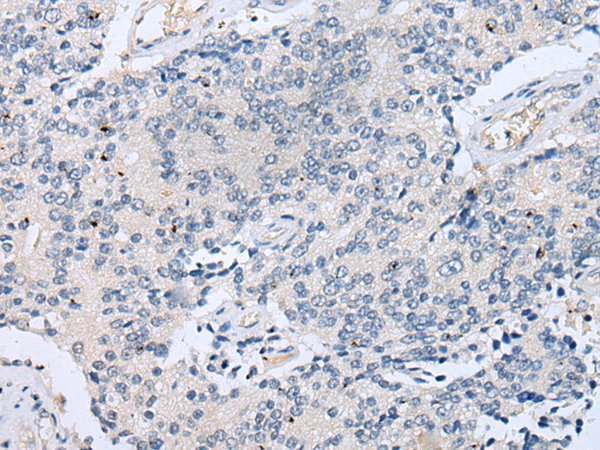
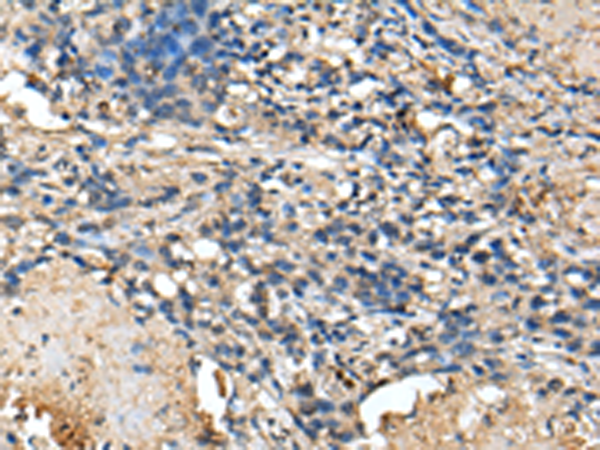
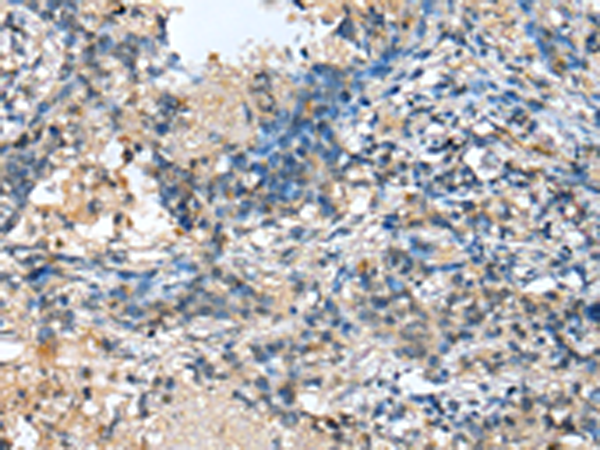

-
分类: 科研抗体货号: P09162别名: YL8应用: WB,IHC反应种属: Human, Mouse, Rat
-
分类: 科研抗体货号: P09163别名: NOLA1应用: WB,IHC反应种属: Human
-
分类: 科研抗体货号: P09179别名:应用: IHC反应种属: Human
-
分类: 科研抗体货号: P09161别名: cPLA2delta应用: IHC反应种属: Human
-
分类: 科研抗体货号: P09178别名: VMA4; ATP6E1; ATP6EL2; ATP6V1EL2应用: WB,IHC反应种属: Human, Mouse
-
分类: 科研抗体货号: P09157别名: SMR应用: IHC反应种属: Human
-
分类: 科研抗体货号: P09177别名: HHGP应用: WB,IHC反应种属: Human
-
分类: 科研抗体货号: P09156别名: RLP2应用: WB,IHC反应种属: Human
-
分类: 科研抗体货号: P09176别名: 2C4D; MOB1; MOB3; PHOCN; PREI3; CGI-95; MOBKL3应用: WB,IHC反应种属: Human, Mouse, Rat
-
分类: 科研抗体货号: P09155别名: CIB; HEL-S-299应用: WB,IHC反应种属: Human, Mouse, Rat

鄂公网安备42018502007531号
鄂公网安备42018502007531号

